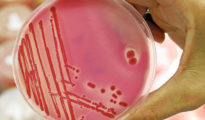

North Face patrocina un campamento transgénero nocturno para que los niños se vistan y ‘exploren’ temas para adultos
The North Face se enfrenta a una reacción generalizada después de que se supo que la marca de ropa para actividades al aire libre está patrocinando un campamento transgénero nocturno para niños. El campamento...

Budding Roses: el campamento de verano en Portland que adoctrina a los niños para sumarlos a las causas de Antifa y BLM
Fundado en 2017, Budding Rose irrumpe como el campamento de verano progresista para que los niños de Portland aprendan a odiar a la policía, a despreciar la seguridad fronteriza y a convertirse en unos auténticos...

Un campamento de verano en Kentucky ofreció a los niños clases de masturbación y sexo con drogas
Emmanuel Alejandro Rondón.- Sexy Summer Camp” es el nombre de un campamento de verano en Kentucky, realizado en 2021, dirigido por activistas progresistas que ofreció clases de masturbación y lecciones sobre...

Entregan un dulce en un campamento feminista y resultan intoxicadas 12 personas
Al menos doce personas fueron intoxicadas tras consumir un dulce llevado como regalo al campamento feminista instalado frente al Palacio Nacional de la República Dominicana en reclamo de la despenalización del...

Un incendio arrasa un campamento de inmigrantes en Lepe con setenta chabolas
Unas setenta chabolas ocupadas por inmigrantes en Lepe (Huelva) han sido destruidas la pasada madrugada por un incendio en el que una persona se ha visto afectada. El 112 ha informado de que a las 4.30 se ha recibido...

Detectado un brote de Covid-19 en un campamento infantil de Soria con ocho positivos, siete en menores
La Delegación Territorial de la Junta de Castilla y León en Soria ha dado a conocer este lunes la detección de un brote de Covid-19 en un campamento en la localidad soriana de Salduero, con ocho positivos, uno...

¡Menos mal que está Vox para impedirlo! (Modo ironía): La Junta de Andalucía colabora en un “Campamento Trans” para niños
Pretende Vox que creamos que sus apoyos a las investiduras de Juan Manuel Moreno (Andalucía), Fernando López Miras (Murcia) e Isabel García Ayuso (Madrid) ha sido gracias a la aceptación por parte del PP y de...

SOLUCIONA garantiza que Málaga no acogerá ningún campamento de inmigrantes si obtiene un buen respaldo electoral el 2-D
Campamento de atención a extranjeros en el Puerto de Motril (Granada) El Puerto de la capital, como los de otras ciudades marítimas andaluzas, acogerá en los próximos meses la instalación de referencia para...
Nueve niños, afectados por una intoxicación alimentaria en un campamento en Málaga
La salmonela es la bacteria que más intoxicaciones alimentarias provoca en verano. Un total de nueve menores de edad han sufrido durante la madrugada de este domingo una posible intoxicación alimentaria en un...

Disturbios violentos en el desalojo de un campamento de activistas en Francia
Antidisturbios franceses en formación para evacuar la zona ocupada La operación de desalojo de un campamento de activistas en el noroeste de Francia, donde estaba prevista la construcción de un aeropuerto, se...

El Barrio Latino de Madrid estalla: ahora tiene un campamento de gitanos rumanos
La dejadez municipal en que se encuentra la zona de Bellas Vistas, conocida como el Barrio Latino, no deja de sumar sorpresas desagradables. El nuevo capítulo de la falta de civismo, de dosis mínimas de convivencia...

El Ayuntamiento de Jalón (Alicante) enseña a las niñas en un campamento de verano a vestir el velo islámico sin el consentimiento de sus padres
DS.- El Ayuntamiento alicantino de Jalón (Compromís) disfrazó como una actividad “multicultural” el adoctrinamiento a las niñas durante las actividades incluidas en un campamento de verano. La historia...

La mayoría de campamentos de verano no están preparados para atender a los niños alérgicos
Rocío Jiménez.- La mayoría de campamentos de verano no están preparados para atender a niños alérgicos y asmáticos, ya que carecen de personal formado, de protocolos de actuación en caso de anafilaxia, e...

Violada una intérprete a punta de cuchillo en las inmediaciones del campamento de inmigrantes de Calais, en el norte de Francia
Tiendas y refugios improvisados en el campamento de Calais Una intérprete de pastún que acompañaba a un periodista freelance en el campamento de inmigrantes de Calais, en el norte de Francia, fue violada en la...

De parias en Siria a aburguesados en Europa: Cientos de refugiados abandonan un campamento griego y exigen mejores instalaciones
Cientos de refugiados alojados en el campamento de la localidad griega de Kátsikas (norte del país) han dejado ese lugar y se han asentado en el parque del pueblo más cercano como protesta por el retraso de su...

Violento ataque a una periodista en un campamento de inmigrantes en Francia
El momento del ataque sufrido por las periodistas en Calais Armados con cuchillos y gas pimienta, los tres inmigrantes abordaron a la periodista Teun Voeten como un enjambre. Maaike Engels, que tenía la cámara...

Canadá abrirá su primer campamento de verano para niños transgénero y de género ambiguo
BD.- El “Campamento Seis Colores”, el primero en Quebec, Canadá, que ofrecerá a los niños transgénero de 7 a 15 años de edad un campamento dedicado a ellos, se estrenará este verano. El campamento...






